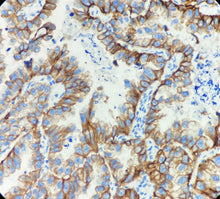
Charger l'image dans la galerie, CK CAM 5.2 (DA126)

Cytokératine CAM5.2
Hôte : souris
Localisation : Cytoplasme
Récupération de l’épitope par EDTA
Introduction :
CAM5.2 est une cytokératine également connue sous le nom de kératine de bas poids moléculaire (48 kDa et 52 kDa), correspondant aux numéros 7 et 8 de la classification de Moll. Elle est spécifiquement exprimée dans l’épithélium glandulaire, mais absente des cellules squameuses stratifiées et de l’urothélium.
Ses principales valeurs diagnostiques comprennent :
① Son rôle de marqueur spécifique de l’épithélium glandulaire, permettant de distinguer efficacement les adénocarcinomes (positifs) des carcinomes épidermoïdes (négatifs) ;
② Son utilité pour différencier le carcinome hépatocellulaire et le carcinome à cellules rénales des tumeurs mésenchymateuses en pathologie hépatique et rénale ;
③ L’amélioration de la précision de la classification des tumeurs épithéliales lorsqu’elle est utilisée en association avec des kératines de haut poids moléculaire (telles que CK5/6).
Il convient de noter que l’anticorps CAM5.2 peut présenter une réactivité croisée avec certains carcinomes épidermoïdes peu différenciés, ce qui nécessite une interprétation intégrée avec d’autres marqueurs.
Contrôle positif : Tissu d’adénocarcinome pulmonaire
| DMRDB144 | 0.1ml, 0.5ml, 1ml | Concentré |
| DMRDB144 | 3ml, 6ml, 10ml | Ready to use |